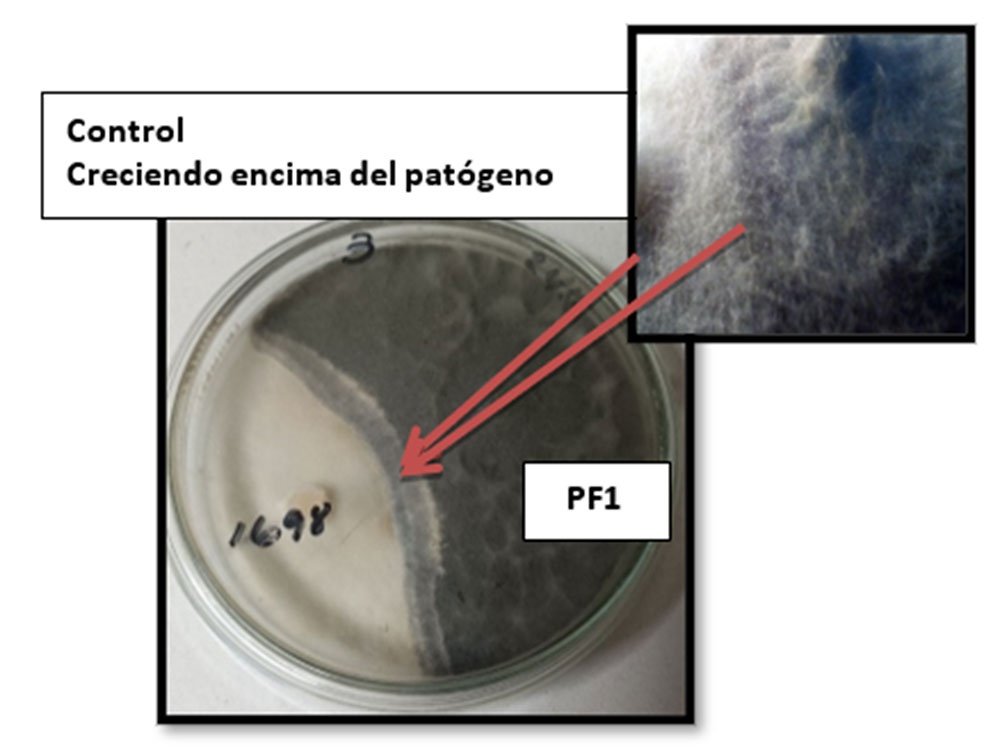
Enfrentamiento de las colonias de la cepa control contra el patógeno Macrophomina phaseolina (PF1)

La revista Agrotecnia de Cuba con e-ISSN: 2414-4673 | p-ISSN: 0568-3114 y e-RNPS: 2120 | p-RNPS: 0353, se funda en 1963 y es editada por el Instituto de Investigaciones Fundamentales en Agricultura Tropical “Alejandro de Humboldt” de Cuba. Está compuesta por un volumen anual bajo el sistema de publicación continuo (enero-diciembre) para aumentar la inmediatez de sus publicaciones. Desde su fundación, devino publicación de competencia en el campo de las Ciencias Agrícolas. Publica investigaciones originales e inéditas en españole inglés devenidas como artículos originales, comunicaciones cortas y artículos de revisión, en las especialidades de recursos fitogenéticos, recursos microbianos, sociología agrícola, fisiología vegetal y poscosecha, manejo de cultivos, protección de plantas y agricultura urbana, suburbana y familiar.
Todos los documentos enviados son sometidos a un proceso de revisión por pares, a doble ciego, y emplea Open Journal Systems para gestionar sus contenidos en línea. Esta revista provee acceso gratis, libre e inmediato a su contenido, para fomentar mayor intercambio de conocimiento global. No establece períodos de embargo, ni cobra ningún arancel vinculado con el proceso de evaluación de pares, procesamiento o publicación de los documentos. Aquellos autores que tengan publicaciones en esta revista, aceptan los términos de la Licencia CC Reconocimiento-NoComercial 4.0 Internacional (CC BY-NC 4.0), bajo los cuales serán difundidos todos sus contenidos.
Número actual
Vol. 49 (2025): enero-diciembre
Publicado: 2025-01-01
Artículos Originales
Efectos del ácido piroleñoso en la respuesta agronómica del maíz (Zea mays L.), cultivar Tusón
https://cu-id.com/2120/v49e01
Introducción del sistema de gestión de calidad en el Banco Central de Germoplasma de Cuba
https://cu-id.com/2120/v49e02
Caracterización de suelos de tres fincas de Güira de Melena, Artemisa, para su uso y manejo sostenible
https://cu-id.com/2120/v49e04
Influencia del método de conservación en las características morfológicas y metabólicas de cepas de Azotobacter sp.
https://cu-id.com/2120/v49e05
Determinación de las fases reproductivas de cultivares de garbanzo (Cicer arietinum L.) en la provincia Granma
https://cu-id.com/2120/v49e06
Enriquecimiento del herbario del INIFAT a través de colecta en áreas protegidas de Cuba
https://cu-id.com/2120/v49e07
Formación de capacidades técnicas para la reducción de las pérdidas y desperdicios de alimentos en Cuba
https://cu-id.com/2120/v49e08
Efecto de la salinidad in vitro sobre la germinación del frijol común (Phaseolus vulgaris L.)
https://cu-id.com/2120/v49e09
Contribución del banco central de germoplasma de Cuba al desarrollo de los sistemas alimentarios
https://cu-id.com/2120/v49e10
La conservación de la agrobiodiversidad y su impacto en sistemas agroalimentarios cubanos
https://cu-id.com/2120/v49e11
Aislamiento y caracterización de hongos fitopatógenos de cultivares de leguminosas en la provincia La Habana, Cuba
https://cu-id.com/2120/v49e12
Control biológico de Macrophomina phaseolina (Tassi) mediante cepas de Trichoderma ssp. y Cladobotryum semicirculare
https://cu-id.com/2120/v49e13
Caracterización morfológica de cultivares de pimiento (Capsicum annuum L.) sometidos a estrés inducido por NaCl
https://cu-id.com/2120/v49e14
Recomendaciones para el método de análisis en la determinación de sales solubles en el suelo
https://cu-id.com/2120/v49e16
Empleo de la biofertilización para potenciar el cultivo de la manzanilla (Matricaria recutita L.)
https://cu-id.com/2120/v49e20
Evaluación de cultivares comerciales de arroz (Oryza sativa L.) durante la época de frío, en la provincia Granma
https://cu-id.com/2120/v49e21
Artículos de revisión
Estado actual y perspectivas del biofertilizante DIMARGON®
https://cu-id.com/2120/v49e03